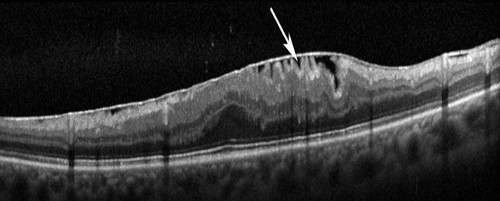

OCT: O que é, como funciona e por que é tão importante para o diagnóstico ocular?
Entre os avanços tecnológicos na oftalmologia, o OCT (Tomografia de Coerência Óptica) se destaca como um dos exames mais modernos e indispensáveis para diagnosticar e
Ocorre a membrana epiretiniana quando na superfície da retina há proliferação de células sobre a mácula formando uma membrana. Esta membrana tende a contrair, levando à distorção da anatomia macular e da visão.
Distorção da imagem e dificuldade para leitura são os principais sintomas.
Normalmente afeta indivíduos acima de 40 anos e pode ser idiopática (sem causa definida) ou secundária a doenças da retina como diabetes, inflamações oculares, entre outros.

Tomografia de retina mostrando uma membrana na superfície da retina
O diagnóstico é feito através do mapeamento de retina (fundo de olho) e confirmado com tomografia da retina (OCT).
A prevenção da membrana epiretiniana não é possível, mas o exame de rotina com o oftalmologista permite sua detecção precoce.
O tratamento é cirúrgico com cirurgia de vitrectomia e remoção da membrana com uma pinça especial de retina.


Entre os avanços tecnológicos na oftalmologia, o OCT (Tomografia de Coerência Óptica) se destaca como um dos exames mais modernos e indispensáveis para diagnosticar e

Esta tecnologia revolucionária permite um diagnóstico mais detalhado e não invasivo das condições que afetam a retina e a circulação ocular. Na Clínica Roisman, oferecemos

Esses sintomas são sim preocupantes e podem indicar condições oculares, que exigem atenção imediata de um especialista. Se você ou um familiar estão enfrentando dificuldades